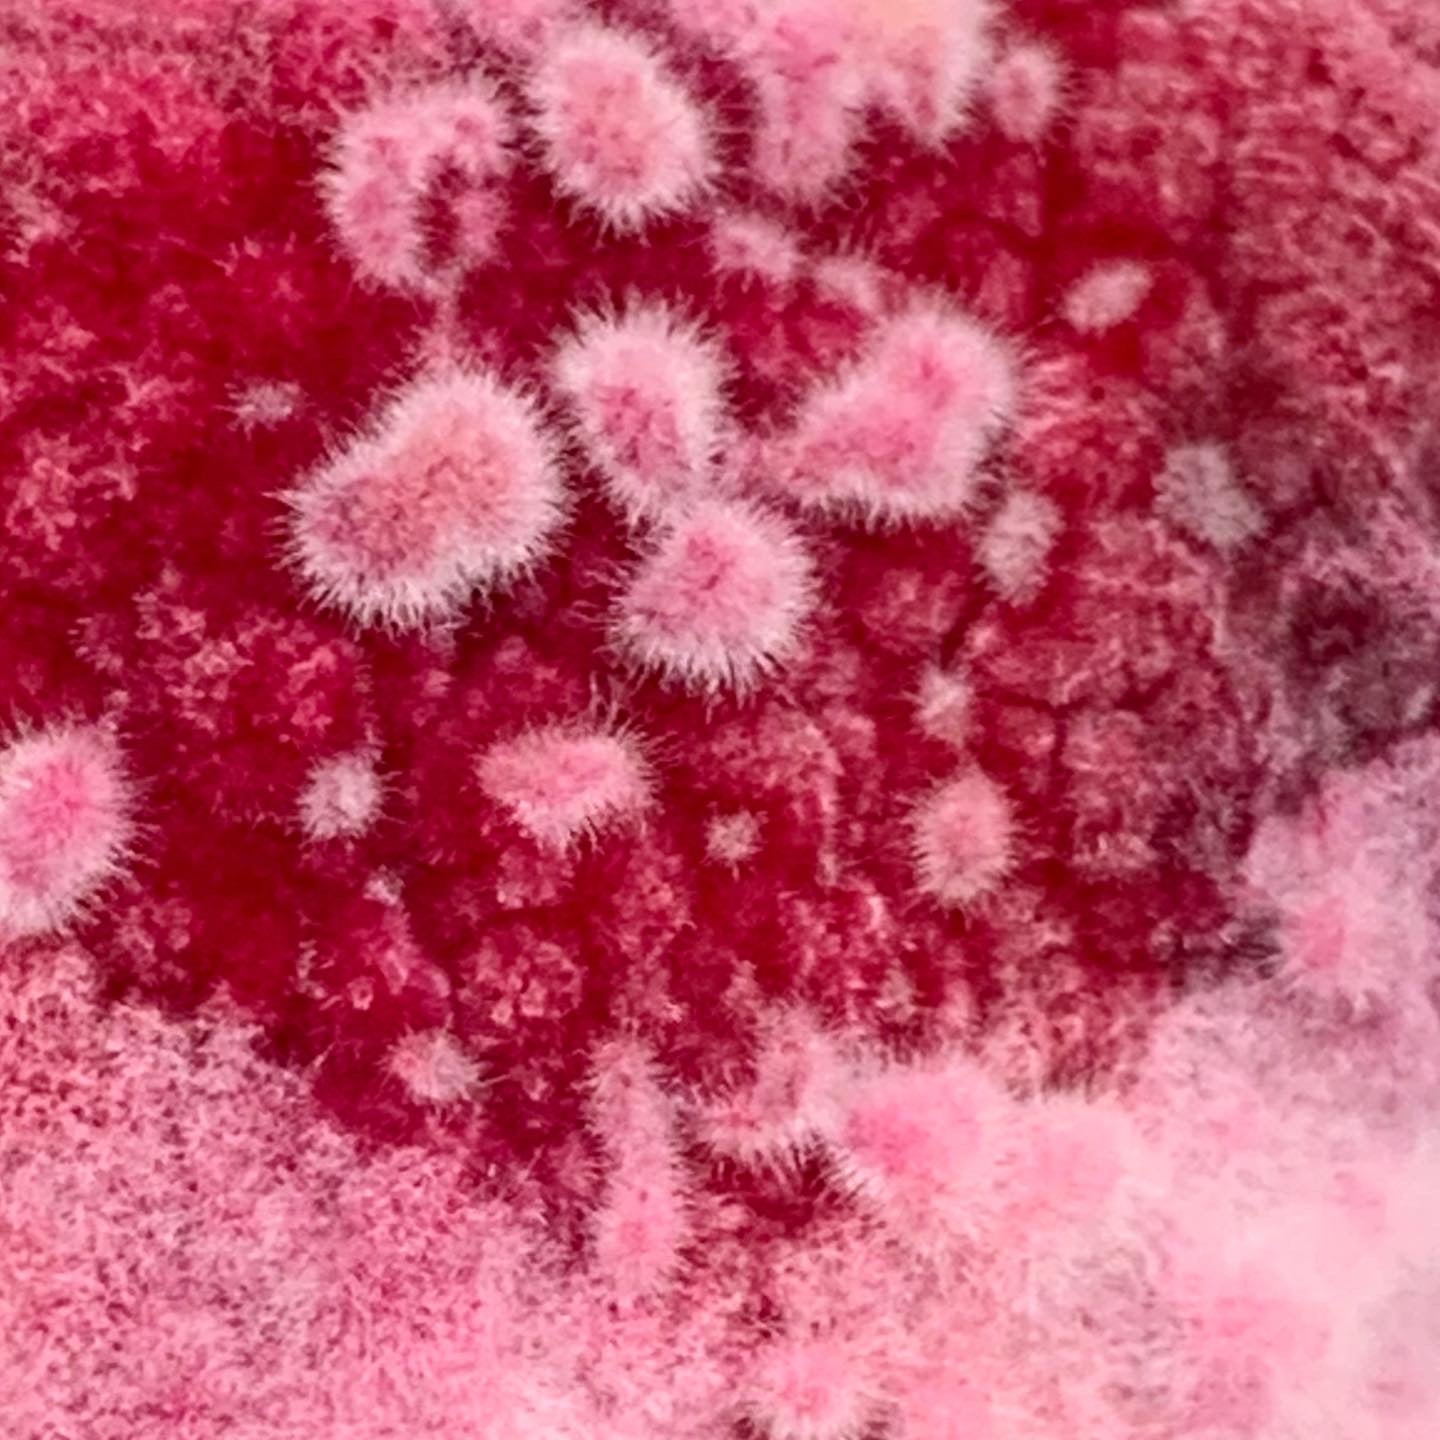

professionals
Nous sommes un laboratoire de fermentation et d’expérimentation. En plus de nos fabrications, nous proposons nos services aux professionnels de la restauration.
Notre laboratoire est à votre disposition pour :
— vous former à nos techniques de fermentation
— réaliser des misos sur mesure
— développer des saveurs à partir de koji frais ou torréfié
— sélectionner nos pépites — tamari, moromi — issues de la fermentation
Contactez-nous pour tout projet fermenté : adondelab@gmail.com
Vive l'umamitude !